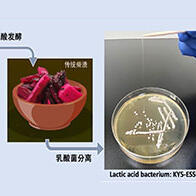
东京科学大学从“柴渍”腌菜中发现新型乳酸菌，独特结构形成高粘性

嵌合抗原受体T细胞疗法(CAR-T细胞疗法)在白血病、恶性淋巴瘤及多发性骨髓瘤等血液癌领域效果尤其显著,针对各类实体癌,以临床应用为目标的研发工作也在积极推进之中。然而,在部分血液癌患者得以治愈的同时,也有不少复发案例。
京都大学研究生院医学研究科发育儿科学的泷田顺子教授、平松英文讲师(现任近畿大学医学部儿科讲师)、加藤格讲师、三上贵司特定研究员(现任该研究科附属癌症免疫综合研究中心特定助教)、该研究科血液内科学的高折晃史教授、大阪大学感染症综合教育研究基地感染症与生体防御研究部门的James Wing教授等人组成的研究团队发现,在针对难治性前体B细胞急性淋巴细胞白血病(BCP-ALL)的复发患者使用CD19 CAR-T细胞疗法时,细胞制剂内特定细胞——4MD CAR-T细胞较多时,治疗效果较好。这种CAR-T细胞的免疫抑制性腺苷产生量较少,具备可长期存活的记忆T细胞性质,因此被认为能够有效清除癌细胞。相关研究成果已发表在期刊《Cell Reports Medicine》上。

图1 接受CD19 CAR-T细胞(tisagenlecleucel)治疗的BCP-ALL患者多组学分析(使用 BioRender 绘制。作者:京都大学 三上贵司,使用许可:CC BY 4.0。)
研究团队着眼于CD19 CAR-T细胞疗法疗效好与疗效不好的患者之间有何差异,开展了可预测治疗效果的生物标志物探索研究。研究以2019年至2023年间在京都大学医学部附属医院接受给药治疗的BCP-ALL患者(儿童16例、年轻成人3例)为对象,在治疗前后的时段内,时序性地采集CAR-T细胞制剂、血液、骨髓液并进行分析。研究结合质谱流式细胞术(CyTOF)、微滴式数字PCR、基因表达分析、细胞检测等多种技术手段展开,对CAR-T细胞进行了多维度的评估。
运用CyTOF的细胞标志物分析发现,当CAR-T细胞制剂中,具备CD38阴性、CD73阴性、Tim3阴性、HLA-DR阳性特征的T细胞(4 marker defined: 4MD)较多时,治疗效果较好且不易复发。在4MD的标志物中,CD38与CD73参与细胞外腺苷的产生,而腺苷已知具有免疫抑制作用。T细胞的检测实际证实了4MD CAR-T细胞腺苷产生较少。此外,基因表达分析揭示,4MD CAR-T细胞的氧化磷酸化及线粒体活性较高,具备记忆T细胞的特征,易于长期维持免疫活性。研究认为,4MD CAR-T细胞正是凭借这些特性,可有效清除白血病的癌细胞,助力提升治愈率。
该结果也在另一项既往研究的单细胞RNA-seq数据中得到验证:根据4MD标志物特征将患者分为两组后,证实接受4MD标志物高占比CAR-T细胞制剂给药的患者复发率更低。
4MD标志物与T细胞的活化、耗竭等免疫学性质相关,可能同样适用于靶向其他抗原或癌症的CAR-T细胞。今后,为实现这类CAR-T细胞的高效制备,研究团队表示将继续研究从患者体内采集的T细胞是否天然具备相关性质,同时探讨基因导入与培养条件,致力于开发出更高效的CAR-T细胞疗法。
三上特定助教表示:“为了让CAR-T细胞疗法能成为更多患者的希望,我们将继续从肿瘤免疫学的视角出发,以革新新的治疗方法为目标,不懈努力。”
原文:《科学新闻》
翻译:JST客观日本编辑部
【论文信息】
期刊:Cell Reports Medicine
论文:CAR-T cells with the CD38⁻CD73⁻Tim-3⁻HLA-DR⁺ phenotype predict the efficacy of tisagenlecleucel as a treatment for B cell precursor ALL
DOI:doi.org/10.1016/j.xcrm.2025.102576